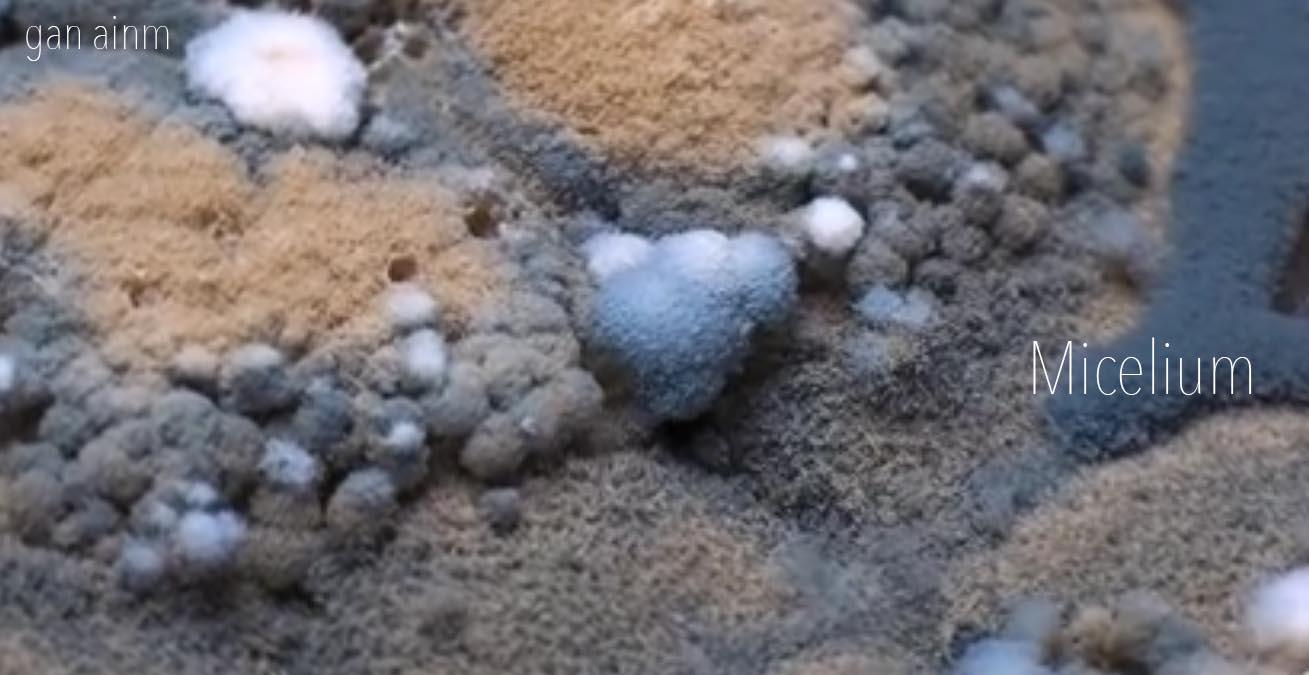

“El tiempo es un niño que juega con los dados; el reino es de un niño. ”
“Time is a child playing at draughts, a child’s kingdom”.
Heráclito

“El tiempo es un niño que juega con los dados; el reino es de un niño. ”
“Time is a child playing at draughts, a child’s kingdom”.
Heráclito